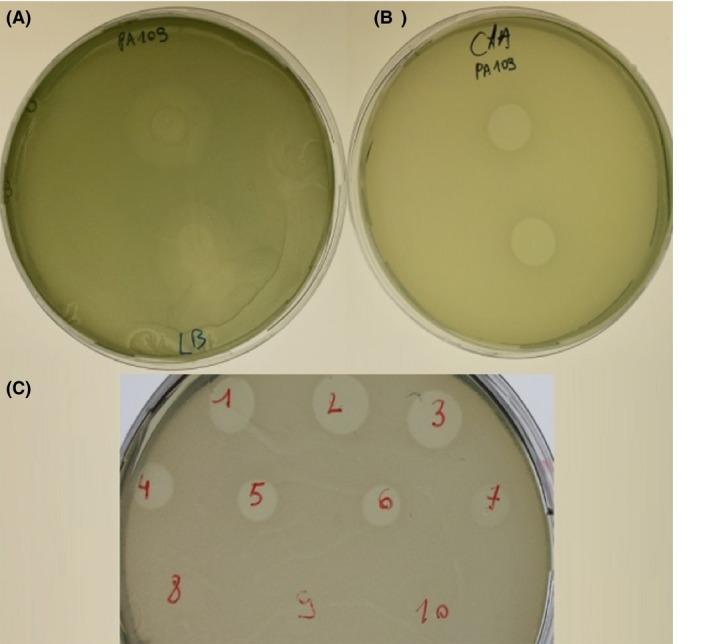
https://cdn.ncbi.nlm.nih.gov/pmc/blobs/d89d/4905994/8b236fdd844f/MBO3-5-413-g004.jpg

从铜绿假单胞菌囊性纤维化临床分离株中鉴定出具有核糖核酸酶活性的细菌素——绿脓菌素S6,并对其进行功能分析。
Identification and functional analysis of a bacteriocin, pyocin S6, with ribonuclease activity from a Pseudomonas aeruginosa cystic fibrosis clinical isolate.
作者信息
Dingemans Jozef, Ghequire Maarten G K, Craggs Michael, De Mot René, Cornelis Pierre
机构信息
Department of Bioengineering Sciences, Research group Microbiology and VIB Department of Structural Biology, Vrije Universiteit Brussel, Pleinlaan 2, Brussels, 1050, Belgium.
Department Microbial and Molecular Systems, Centre of Microbial and Plant Genetics, KU Leuven Kasteelpark Arenberg 20 - bus 2460, Heverlee, B-3001, Belgium.
出版信息
Microbiologyopen. 2016 Jun;5(3):413-23. doi: 10.1002/mbo3.339. Epub 2016 Feb 9.
S-type pyocins are bacteriocins produced by Pseudomonas aeruginosa isolates to antagonize or kill other strains of the same species. They have a modular organization comprising a receptor-binding domain recognizing a surface constituent of the target bacterium, a domain for translocation through the periplasm, and a killing or toxic domain with DNase, tRNase, or pore-forming activity. Pyocins S2, S3, S4, and S5 recognize TonB-dependent ferri-siderophore receptors in the outer membrane. We here describe a new nuclease bacteriocin, pyocin S6, encoded in the genome of a P. aeruginosa cystic fibrosis (CF) clinical isolate, CF_PA39. Similarly to pyocins S1 and S2, the S6 toxin-immunity gene tandem was recruited to the genomic region encoding exotoxin A. The pyocin S6 receptor-binding and translocation domains are identical to those of pyocin S1, whereas the killing domain is similar to the 16S ribonuclease domain of Escherichia coli colicin E3. The cytotoxic activity was abolished in pyocin S6 forms with a mutation in the colicin E3-equivalent catalytic motif. The CF_PA39 S6 immunity gene displays a higher expression level than the gene encoding the killing protein, the latter being only detected when bacteria are grown under iron-limiting conditions. In the S1-pyocinogenic strain P. aeruginosa ATCC 25324 and pyocin S2 producer P. aeruginosa PAO1, a remnant of the pyocin S6 killing domain and an intact S6-type immunity gene are located downstream of their respective pyocin operons. Strain PAO1 is insensitive for pyocin S6, and its S6-type immunity gene provides protection against pyocin S6 activity. Purified pyocin S6 inhibits one-fifth of 110 P. aeruginosa CF clinical isolates tested, showing clearer inhibition zones when the target cells are grown under iron limitation. In this panel, about half of the CF clinical isolates were found to host the S6 genes. The pyocin S6 locus is also present in the genome of some non-CF clinical isolates.
S型绿脓菌素是由铜绿假单胞菌分离株产生的细菌素,用于拮抗或杀死同一物种的其他菌株。它们具有模块化结构,包括识别靶细菌表面成分的受体结合结构域、穿过周质的转运结构域以及具有DNA酶、tRNA酶或成孔活性的杀伤或毒性结构域。绿脓菌素S2、S3、S4和S5识别外膜中依赖TonB的铁载体受体。我们在此描述一种新的核酸酶细菌素——绿脓菌素S6,它由铜绿假单胞菌囊性纤维化(CF)临床分离株CF_PA39的基因组编码。与绿脓菌素S1和S2类似,S6毒素-免疫基因串联体被招募到编码外毒素A的基因组区域。绿脓菌素S6的受体结合和转运结构域与绿脓菌素S1相同,而杀伤结构域与大肠杆菌大肠菌素E3的16S核糖核酸酶结构域相似。在与大肠菌素E3等效的催化基序发生突变的绿脓菌素S6形式中,细胞毒性活性被消除。CF_PA39 S6免疫基因的表达水平高于编码杀伤蛋白的基因,后者仅在细菌在铁限制条件下生长时才被检测到。在产生绿脓菌素S1的铜绿假单胞菌ATCC 25324菌株和产生绿脓菌素S2的铜绿假单胞菌PAO1菌株中,绿脓菌素S6杀伤结构域的残余部分和完整的S6型免疫基因位于各自绿脓菌素操纵子的下游。PAO1菌株对绿脓菌素S6不敏感,其S6型免疫基因可提供针对绿脓菌素S6活性的保护。纯化的绿脓菌素S6抑制了所测试的110株铜绿假单胞菌CF临床分离株中的五分之一,当靶细胞在铁限制条件下生长时,显示出更清晰的抑制圈。在该组中,约一半的CF临床分离株被发现携带S6基因。绿脓菌素S6基因座也存在于一些非CF临床分离株的基因组中。